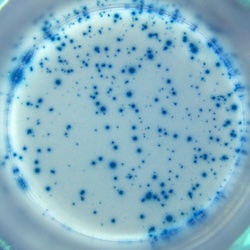

IL-10 specific spots produced by 5x10E4 human PBMC.
Stimulation: PMA/ionomycin.
Stimulation: PMA/ionomycin.
Catalogue Number
CT235-B2
Description
Human IL-10 T cell ELISPOT kit - 2-plate
Price
€ 465.00
staining
Enzymatic
Characteristics
PVDF
Contents
- coating antibody
- biotinylated detection antibody
- Streptavidin-HRP
- TMB substrate
- Blocking stock solution
- Dilution buffer
- Tween-20
- PVDF ELISPOT plates with lids and cover slips
- manual